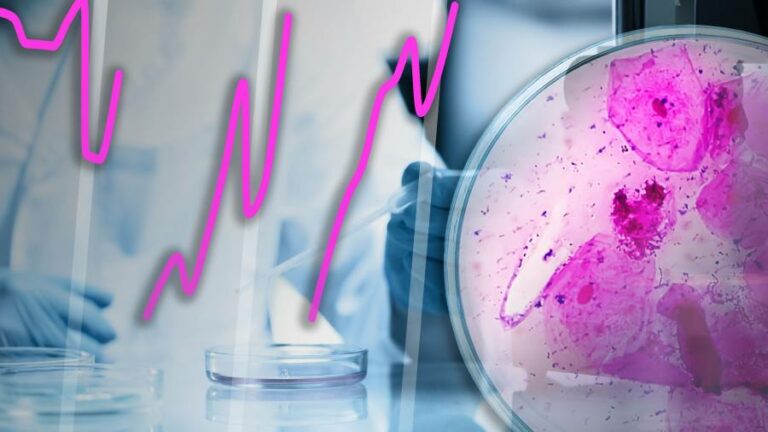
Surge in STIs in England sparks anxiety over reproductive health

England experienced a surge in sexually transmitted infections in 2022 driven by significant increases in gonorrhoea, syphilis and chlamydia, according to figures released by the UK government.
Across all age groups, 83,000 cases of gonorrhoea were diagnosed, the largest number since records began. Syphilis diagnoses are at their highest level since 1948. The latest annual figures follow much lower figures recorded in 2020 and 2021, in part because testing fell during the coronavirus pandemic.
The highest STI diagnosis rates were recorded in younger people. Among 15- to 24-year-olds, diagnoses increased 26.5 per cent in 2022, with cases of gonorrhoea almost doubling.
Chlamydia remains the most frequently diagnosed STI in the UK, with almost 200,000 cases recorded, more than half of the total number of STIs diagnosed. It often has no symptoms but, if left untreated, can cause health complications in women, including pelvic inflammatory disease and infertility. Last year, 690,000 young women were tested in a national screening programme, which found a positivity rate of 10 per cent.
The World Health Organization estimates that more than 1mn diagnoses of STIs are made every day worldwide. Efforts to reduce the number of infections include promoting the regular use of condoms and vaccines, while obstacles include increasing antimicrobial resistance to many antibiotics used to treat STIs.
Alan Smith
Our other charts of the week

The number of foreign graduates granted the right to work in the UK more than doubled in the three months to March compared with the same period last year, according to the Home Office.
In the first quarter of this year, 37,692 graduate visas were issued, up from 17,013 in the first three months of 2022.
Students from India account for the largest share of visas, which permit international students to stay in Britain for two years after graduating, or three years if they have completed a PhD. Before the post-study work visa was reintroduced in July 2021, students with bachelor’s or master’s degrees had to find work within four months of graduating.
But some higher education leaders said this was a temporary surge following the easing of Covid-19 restrictions and that numbers would fall, particularly in light of UK home secretary Suella Braverman’s decision to ban most international students from bringing dependants with them.
Countries such as Australia and Canada offered longer post-study stays under certain conditions, said Andrew Bird, head of international marketing at Bournemouth University. “While every other market is expanding this route, the UK is contracting — at a time when attracting overseas students is getting more competitive,” he added.
Georgina Quach
More than a quarter of young people aged 15 to 29 in the EU live in overcrowded households, according to Eurostat.
There are wide variations in the figures on a country-by-country basis: more than 60 per cent of young Romanian adults live in overcrowded households compared with less than 4 per cent of young Cypriots. However, the overcrowding rate is higher for younger adults than the general population for every country in the bloc. The rate of overcrowding for young people is more than twice that of the overall population in Denmark, the Netherlands and Finland.
A person is considered to be living in overcrowded conditions if their household does not have an appropriate number of bedrooms. For example, a couple should have their own room, as should every single person aged 18 and older, while there should be one room per pair of single people of the same gender aged 12 to 17 and one room per pair of children younger than 12.
The figures published are for 2021, a period when concern was expressed for the wellbeing of young people living in lockdown conditions, but the overcrowding rates remain broadly similar to levels seen before the pandemic.
Alan Smith
The UK’s Office for National Statistics used World Environment Day to highlight how households are the largest single contributor to the nation’s emissions.
More than a quarter of the total is related to emissions by consumers, primarily from heating homes and commuting to work by car.
Despite a 57 per cent fall in energy sector emissions from 2006, overall emissions in 2021, the latest figures available, were up 3 per cent compared with 2020 figures. The UK has pledged to reduce economy-wide greenhouse gas emissions by at least 68 per cent by 2030, compared with 1990 levels.
Ian Bott
The number of unilateral restrictions imposed by countries on cross-border trade and investment has grown significantly over the past decade, reversing the trend of liberalisation seen during most of the 20th century.
In 2022, restrictions on goods, services and investment jumped 14 per cent, compared with the previous year, to more than 2,600, according to Global Trade Alert data compiled by the IMF. This is more than six times higher than in 2013.
During the pandemic, many countries restricted exports of medical goods and foodstuffs. More recently, Russia’s war in Ukraine and competition between countries such as the US and China have fomented further protectionism.
Trade restrictions, such as tariffs and export bans, have proliferated in sectors including commodities and semiconductors, which are often viewed as central to national security.
Alex Irwin-Hunt
Welcome to Datawatch — regular readers of the print edition of the Financial Times might recognise it from its weekday home on the front page.
Do you have thoughts on any of the charts featured this week — or any other data that has caught your eye in the past seven days? Let us know in the comments.
Keep up to date with the latest visual and data journalism from the Financial Times:
-
Data Points. The weekly column from the FT’s chief data reporter John Burn-Murdoch.
-
Climate Graphic of the Week is published every week on our Climate Capital hub page.
-
Sign up to The Climate Graphic: Explained newsletter, free for FT subscribers. Sent out every Sunday, a behind-the-scenes look at the most topical climate data of the week from our specialist climate reporting and data visualisation team.
-
Follow the FT on Instagram for charts and visuals from significant stories.
-
Follow FT Data on Twitter for news graphics and data-driven stories from across the FT.